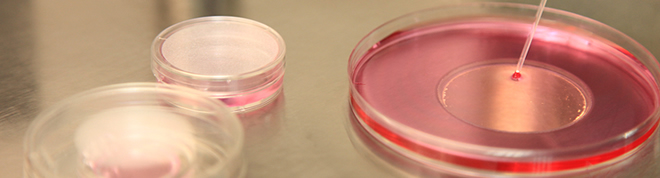
ivf doctors

مختبرنا
إن أخذ البويضات من الأمهات بطريقة صحيحة، ومن ثم القيام بإجراءات أطفال الأنابيب بالطرق التقليدية أو بطريقة الحقن المجهري ومن بعدها تهيئة الجنين بجودة عالية من أجل عملية النقل تشكل البؤرة الأساسية للمعالجة في مختبراتنا الموجودة في مركز أطفال الأنابيب. ومن ناحية منع حدوث الحمل المتعدد يتم الإستمرار في عملية الزرع بإختيار جنين واحد أو جنينين حتى مرحلة الكيس الأريمي (جنين اليوم الخامس) ، وتقع مهمام هذه الإجراءات على عاتق خبير الأجنة الذي يمارس مهامه الدقيقة مع الكوادر الفنية في مختبرنا .
يلعب المختبر دورا ً حساسا ً وعالي الأهمية في المعالجات الخاصة بأطفال الأنابيب، وتبعا ً لذلك يجب أن يكون المختبر مجهزا ً بالأدوات والمعدات الضرورية، كما يجب على الأعمال المخبرية أن تسير وفق خطة نظامية معينة. وبالإضافة إلى ذلك يجب قيام خبراء الأجنة بالدراسات الدقيقة ومتابعة نظام حساس بجدية فائقة فيما يتعلق بمراقبة ومتابعة الجودة. ولمَّا كانت عناصر مدى النجاح كامنة في التفاصيل الدقيقة فإن القيام بفحص ومراقبة الأجهزة المخبرية وأجواء المخبر بشكل دوري ومنتظم وإزالة العوائق والعراقيل فورا ً أمر في بالغ الأهمية والضرورة.
إن العزل الكامل والتعقيم متطلبات أساسية في مختبرات الأجنة وطب الذكورة وجميع العمليلت والإجراءات التي يتم تنفيذها بقصد التشخيص المرضي والمعالجات تتم وفق المعايير الدولية والمعايير المحلية المعتمدة. كما أن الدخول إلى المختبر والخروج منه محدد على أن يكون في أدنى الدرجات والدخول إلى المختبر مقتصر على المسسؤولين المتختصين شريط الدخول إلى المخبر والتواجد فيه بثياب وبدلات مخصصة لتلك الأغراض. ومن ناحية أخرى يتم تنفيذ أعمال تركيب المعدات والأجهزة التي تستعمل في المختبر وصيانتها وتعييرها بشكل دوري ومبرمج من قبل تقنيين مؤهلين في هذا المضمار. كما يتم تنفيذ تنظيف المختبريوميا ًفي وقت مبكر قبل البدء بأعمال المختبر اليومية.
يتم في مختبرنا فحص ومراقبة سوية غاز ثاني أكسد الكربون وغاز الأوكسجين ونسبة الرطوبة وسوية الماء بإستمرار في المكائن والمعدات المخبرية التي يطلق عليها إسم الحاضنات التي يتم حفظ الأجنة بداخلها. ويتم في حالة ظهورأي إنحراف في السويات والقيم المحددة القيام فوراً بإجراء ماهو ضروري. ويتم مراقبة درجة حرارة الكبائن التي تحفظ فيها البويضات والنطاف والأجنة ودرجة حرارة الثلاجات وأسطح المجاهر المستعملة في عملية الحقن المجهري والوحدات الحرارية ومن ثم تسجل درجات الحرارة هذه في القوائم الخاصة. والجدير بالذكر بأن جودة الهواء في المختبر لها أهمية خاصة جدا ً.
ونظام التهوية الخاص بمركز أطفال الأنابيب منفصل بشكل خاص عن نظام التهوية الخاص بالمبنى. ويستعمل في مركزنا إضافة إلى مرشحات (H.E.P.A) المعروفة مرشحات (C.O.D.A) بالإضافة إلى مرشحات الكربون من أجل المركبات العضوية الطيارة. والجدير بالذكر . وهذه المرشحات موجودة فقط في عدد محدود جدا ً من المختبرات . ومن الجدير بالذكر أن نبين بأن تكنلوجية هذه المرشحات تؤمن جودة ومثالية عالية في الهواء المرشح.
ويتم تغيير المرشحات على فترات محددة بشكل دوري. كما يتم تغيير المواد الكيميائية التي تحفظ فيها الأجنة مع كل طلبية جديدة وتقاس درجة الحموضة (pH) وقد يتم اللجوء إلى تغيير أو تعديل عيارات الحاضنة حسب المتطلبات، كما يتم من ناحية أخرى قياس مستةى النتروجين السائل في الحاويات المخبرية التي تحفظ الأجنة المجمدة مرتين في الأسبوع الواحد حيث يتم إضافة كميات من النتروجين السائل في حالة وجود نقص في السوية المحددة.
وخلال عملية مراقبة الجودة يتم تسجيل سائر المعطيات المتعلقة بالثوابت التي تقاس وتراقب عن كثب وذلك بكل دقة وحذر. إلاَّ أن أهم شرط بهذا الصدد هو مدى جودة الخبراء العاملين في مختبر الأجنة الذين يقومون بتنفيذ أعمال مراقبة الجودة ومدى حسن الأداء.
ويتألف الفريق الذي يعمل في مختبر مركزنا من خبراء مؤهلين يقومون بتقديم خدماتهم وجهودهم في هذا المجال منذ العديد من السنوات.
 |
 |
 |
 |
 |
 |
 |
 |
 |
 |
 |
 |
بحث
 p
p






